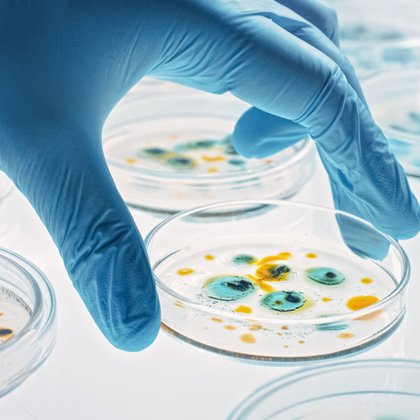
Tweet card summary image

NC State Vet Medicine
@NCStateVetMed
Followers
16K
Following
1K
Media
5K
Statuses
17K
Official account of #NCStateVetMed. See how we’re shaping the future of veterinary medicine and equipping the next generation of healers. 🐺🐾
Raleigh, NC
Joined July 2009
What does "healthy aging" look like? Misperceptions of discomfort, disability and poor quality of life can affect decisions we make. In an international collaboration, Dr. Natasha Olby and Dr. Margaret Gruen document aging is not fixed but modifiable. https://t.co/0nUL8avLxS
1
0
0
During #AntibioticAwarenessWeek, it's important to understand what antibiotics are and how to use them appropriately. Overuse has led to antimicrobial resistance, curtailing our arsenal of bug-fighting medicines and leaving us vulnerable to infections. https://t.co/qRha7oydkz
news.cvm.ncsu.edu
0
0
2
A new study — with Dr. Michael Rahe as the corresponding author — shows that the response of T cells rather than production of antibodies is what makes current vaccines against porcine reproductive and respiratory syndrome virus effective. https://t.co/yAhbjszmTI
0
1
0
Dr. Lydia Love has become the first DVM in the country to earn the Certified Professional in Patient Safety credential. She also is taking on the new role of director of patient safety at the @NCState Veterinary Hospital. What's next: https://t.co/1VtoZOgXzi
0
0
2
On #VeteransDay, we salute our @NCState students who served in uniform before putting on scrubs. Today, Olivia Di Ruzza and Joe Hampton will be thinking of friends still serving and reflecting on military moments already shaping their veterinary careers. https://t.co/BQW0rwn6Mx
0
3
6
Our students, faculty and staff are #problemsolvers and #innovators, providing world-class care and making ground-breaking discoveries each day. This fall, researchers have won millions in NIH grants. Residents were tops in research, papers and posters. https://t.co/J7DMvUOfVz
0
1
0
Clinical Trials: Two studies needing dogs with bladder cancer. Use links for more info & eligibility reqs. Please share! PROBIOTIC: https://t.co/RPA21gelUA IMMUNOTHERAPY: https://t.co/Pk6VVR3PV0
0
1
0
Clinical Trials: Dogs. We're looking for canine participants. Use links for more info & eligibility reqs. Please share! Dogs - Spontaneous Pneumothorax: https://t.co/k2U2PsmmcM Dogs - Chronic Kidney Disease: https://t.co/egh4TBDFQh Dogs - Osteoarthritis: https://t.co/QpT9f0TRMB
0
1
5
Clues from cow collars are helping keep our dairy herd hardy. The electronic monitoring system, in place since our new dairy barn opened last year, has helped reduce serious illness in the animals and kept vet students up-to-date on industry technology. https://t.co/nDeU0VsMXk
0
0
1
With a $5.5 million #NIH grant, NC State veterinary behavioral specialist Dr. Margaret Gruen has joined the national #HEAL fight against #opioidaddiction. Her project aims to find ways to measure how chronic pain affects how dogs think and behave. https://t.co/vHPX3dZpIH
0
1
5
🐱 Planning for Cat Camp 2026 is underway after the success of our inaugural event this month! 🐱 The camp brought together 11 leading feline clinician scientists and 35 vet residents from 28 colleges to jumpstart careers in feline research and medicine.
news.cvm.ncsu.edu
0
1
1
Veterinary colleges face an increasing shortage of educators needed to train DVMs and advance critical research. NC State stepped up. Our Veterinary Academic Leaders Program welcomed 15 new residents, bringing the total number of fellows to nearly 40! 👏 https://t.co/Ecq8lL25wG
1
3
6
Vet student Joseph Richardson is the son and grandson of trail-blazing doctors who spent decades serving his rural Hertford County #NC community. Richardson is planning to care for people, too — by caring for their animals. The question is which ones? https://t.co/O2dkE0kGhi
0
0
0
Our students, faculty and staff at #NCStateVetMed are problem-solvers, innovators and life-changers, providing world-class care and making ground-breaking discoveries every day that advance animal and human health. Learn about our most recent accolades: https://t.co/sGzm5M7bUu
0
1
0
Clinical Trials: We're looking for participants. Use links for more info & eligibility requirements. Please share! Cats - CHF: https://t.co/OZXywWAo7s Dogs - IMHA: https://t.co/3QGeivl4CT Bladder Cancer: https://t.co/zgDQQhZ0Su Mammary Tumors: https://t.co/HzTm7SQJtZ
1
1
2
The NC State College of Veterinary Medicine has created its first dry lab to support the critical work of Dr. Gustavao Machado, whose RABapp helps authorities in 36 states, including NC, track disease outbreaks among hog, poultry and cattle operations. https://t.co/3hPg5tJ5Du
0
3
5
It's Spotlight Saturday! ✨ Learn about @ncstatevetmed's inaugural Randall B. Terry Jr. Rural Veterinary Scholars Program: https://t.co/1ZltI37bAv
0
1
3
How does a brain develop inside an embryo? NC State scientist Eric Brooks has found that cells perform a complicated dance to determine locations and function. Now, he and colleagues have created a cellular atlas to study this delicate part of development. https://t.co/xjtzwFYXVD
1
1
3
In a new study, Dr. Gustavo Machado and team have found that a system to reroute vehicles carrying feed or animals to other farms or market reduces contact between infected and uninfected farms by 42%. @ncagriculture @ncpork #biosecurity Find out more: https://t.co/ynT9WUcS37
1
3
5
We're looking for participants for these studies. Use links for more info & eligibility reqs. Please share! Cats - Chronic Kidney Disease: https://t.co/FGQjf3QQ8J Dogs - Gallbladder Mucocele: https://t.co/byNkjw5Ik5 IMHA: https://t.co/AaZ21QDKil CKD: https://t.co/KcpJyXZ40A
0
2
1